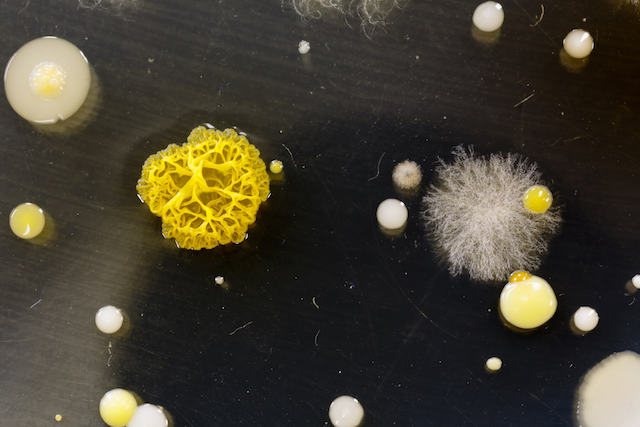
mold and bacteria

Before You Go
Get Your FREE Home Cleaning Guide
Simple action items on how to make your home safer- today!

Most of us have probably heard "Are you flossing enough?" a time or two from our dentists, followed by a long monologue about how important it is for our dental health. It’s like a blast back to those childhood years when a parent wasn’t mad, they were just disappointed at your choices. Sometimes life gets busy and we forget about our dental routines! Luckily, one recent advancement in technology was designed to make our lives a little easier. We’re talking about that trusty water flosser and the long list of benefits that accompany its use. ¹’²’³ Without proper maintenance, though, health hazards like mold in a waterpik can happen in the blink of an eye.
Why is it such a big deal? When mold in a waterpik pops up, it means that every time you’re working to blast away the food between your teeth or the film of whatever else is in your mouth, you’re also showering them with all sorts of microscopic contaminants.⁴ For those out there following the dentist’s recommendations of flossing at least once a day, that’s quite a high volume of foreign particles entering the body.⁵ As you can imagine, this could cause a whole list of issues for your immune system.
Learning how to prevent mold in a waterpik and what to do if any manages to sneak in is key to helping keep your body and mouth happy and healthy. Plus, the thought of flossing with mold is kind of icky, right?
Before getting started on steps to prevent mold in a waterpik, it’s important to know why mold in a waterpik occurs in the first place. That way, these extra steps of avoidance will make more sense, and there’ll be that extra little zest of motivation.
Mold is a type of fungus with over 100,000 species identified so far across the world. Each species reproduces by releasing microscopic spores into the surrounding environment.⁶’⁷ The process is similar to how a dandelion puff releases those fluffy white seeds into the air. Spores, similarly, will catch a ride to wherever that air current leads.
With the lack of discussion on mold in society, there are quite a lot of misconceptions out there, which brings us to our first debunking.
Mold is everywhere, so it’s no big deal when it’s in your home.
Sure, there are mold particles all over. But the distinction is that they’re spaced out all over the big wide world. You’ll more than likely encounter a few while driving to the grocery store, walking into work, or sitting down to eat dinner at a restaurant. The key phrase there was "a few" particles.
Now, picture mold growth in a home. When a spore finds a nice little surface to settle down on (like that water flosser), it will put down roots called hyphae, settle in for the long haul, and start to release those tiny little spores into the surrounding environment. Some species of mold can also create microscopic toxins called mycotoxins when they feel stressed, adding even more specks to the particle party.⁸

The difference between indoor and outdoor mold growth is that when it occurs inside, most of those particles remain trapped in the home. They’re not floating all over the place in nature. Why does this seem like more of a problem nowadays? Thanks to modern building techniques pushing for net-zero energy efficiency, there’s very little air flow between indoor and outdoor environments. Without additional filtering technologies installed, that means that any particle that enters the house will remain inside until actions are taken to remove them.
Reverse back to that little mold growth mentioned above. Taking this into account, all of those particles being released will then build up around the colony, float around the room with the growth, and catch a ride on the air current to other areas of the house. This causes a problem for a few reasons.
In a nutshell, it’s a serious health no-no, which is why actively working to prevent mold in a waterpik or anywhere else inside of a home is a stellar idea.
The good news is that, like seeds, spores are nonliving particles. They will remain tiny little specks until they land on a habitable surface with the elements they need for growth. On the not-so-goo size, mold is a hardy little fungus and only needs four easy things to transition into a living organism.⁹
When the stars align and all four of these are present for 24–48 hours, a mold spore will think it has won the lottery dream home and colonize. It just so happens that a water flosser often has each of these components for growth. Oxygen and temperature are given in the bathroom. Food options abound, from dust, skin cells, mineral buildup, particles from the mouth, you name it. That leaves moisture as the remaining golden nugget. With water literally in the name of the tool, it’s pretty easy to see how mold in a waterpik can occur.
If water is left in this dental hygiene item, all a spore has to do is stumble inside and boom, there’s fungal growth being blasted on your teeth. Which, is definitely not good for your health.
The difficult thing about mold exposure is that no two people respond the same way. While one person who has mold in a waterpik might only experience a recurring sinus infection, another may develop over 30 random symptoms.

There are various components to this fungus among us that make it difficult for researchers to figure out the health implications of exposure.¹⁰’¹¹’¹²’¹³’¹⁴ Factors such as genetics, species of mold, the volume of exposure, length of exposure, presence of mycotoxins, presence of bacteria, and immune system status all play a role. What researchers do know is that individuals with compromised or developing immune systems are at greater risk of developing symptoms faster and to a greater extent.
The ability of mold to affect the body largely rests on how small the particles in question are. Measured in a unit called microns, mold spores, mycotoxins, and bacteria are all small enough to be inhaled, absorbed, and ingested. To give you a better idea, a single micron is 1/1,000 of a millimeter, which means you’d need to line up 1,000 microns to equal the length of two of the tiny lines on a ruler. As you can see, mold spores can range from anywhere from 1–20 µm, bacteria average in at 2 µm and mycotoxins come in at 0.1 µm.
These particles are so small that the EPA categorizes them as particulate matter and breaks them down into two categories, both of which are inhalable.¹⁵
As these particles enter the body, regardless of whether they’re toxic or not, they trigger an immune response. The body will tag them as foreign invaders, and the immune system will go into overdrive. The issue, here, is whether or not the immune system can keep up with the army of particles that come from an indoor mold growth party. Just think of how many are being introduced from flossing while there’s mold in a waterpik. Oftentimes, it can get overrun or malfunction, leading to a long list of symptoms and/or related autoimmune conditions as the toxicity level continues to build up within the body.

Again, you just never know how someone will respond to exposure. That’s why it’s crucial to take action to prevent mold in a waterpik so that the opportunity for chronic symptoms triggered by environmental factors does not occur.
The best way to deal with this fungus among us is to avoid it from occurring in the first place. That means actively taking steps to prevent mold in a waterpik so that your dental health remains pristine.
One of the best ways to tackle prevention is deep cleaning the machine once a month at least, but the more often the better. Keeping the tool clean aids in the removal of potentially harmful particles such as spores, bacteria, and mycotoxins, as well as potential food sources such as organic matter and mineral buildup.It also helps ensure that the machine continues to work properly; a malfunctioning waterpik is an open door for retaining moisture and allowing for mold growth.
Once you’ve got everything set up and ready to go, you can dive in. Make sure to double-check the manufacturer's manual for a list of what can be removed from the tool, as well as its cleaning instructions. Every machine is different, so trust the experts for this task.

While this cleaning regime may seem thorough, it will help prevent mold in a waterpik from happening to you. The ultimate goal is to keep the machine as particle-free and dry as possible.
Adding each of these steps to your waterpik maintenance routine can help ensure you don’t blast harmful particles into your mouth while trying to fight off plaque buildup.

Unfortunately, the best way to handle mold in a waterpik is to get rid of the tool and replace it with a brand new one. For anyone who is hypersensitive to mold, this is especially important to follow.
Once the mold settles inside, all of those particles start dispersing throughout the tool. You can attempt to decontaminate it and remove those harmful particles, but thanks to their small size, it’s almost impossible to ensure they’re all eliminated. Mycotoxins and bacteria are particularly difficult to remove once they have stuck to a surface.
Any particle left behind, whether it be mold, mycotoxins, or bacteria, means that exposure continues and any adverse health reactions will persist. That’s why it’s best to start fresh with a waterpik that isn’t steeped in contamination.
For those not in a position to replace their waterpik, you can attempt to deep clean using the steps above, but complete the process at least three times and remove as many particles as possible. If that mold comes right back or symptoms continue, that contamination is more than likely still present in the machine, and it’s time to throw it in the garbage.
Again, though, it’s best to err on the side of caution and just go ahead and toss it. When it comes to your health, going above and beyond is always worth the investment.
If you’re not giving your dental hygiene tool the side-eye, you’re probably wondering how to tell if mold in a waterpik is a problem for you. The best way to figure out if there’s an issue is to use sight, smell, and feeling.
With over 100,000 species of mold out there, any visible growth can appear in a multitude of colors, shapes, and textures. That means that any visible abnormalities should be considered a problem.
That being said, common colors of mold include green, grey, brown, black, white, yellow, red, or any mixture of these hues. As for textures, growth could appear slimy, velvety, powdery, fluffy, or any combination of these consistencies.
Make sure to check the cracks, crevices, and hard-to-see areas as well, since mold can grow pretty much anywhere.

Mold growth is tricky, which means that it isn’t always visible. There could be growth in hidden areas of the machine, or the colony itself is young and too small to be visible to the naked eye. When this occurs, you need to use your nose to help determine if there’s a problem.
Actively rowing mold often creates a musty, earthy, damp smell as it releases gases called microbial volatile organic compounds (MVOC).¹⁷ If this odor is coming from the waterpik, it points to an invisible problem existing inside.
No visible issues or smells? That still doesn’t mean you’re in the clear because not all mold growth is detectable or creates a stinky smell. In these cases, pay attention to how you feel when around the tool or after using it. If chronic symptoms seem to spark up out of the blue or become worse over time, particularly after being around the device, and no doctor can pinpoint a problem, exposure to mold in a waterpik might be the root cause.
Our bodies are incredible warning systems that will alert us if something’s wrong, including if there’s a contaminant in our indoor environments. It’s up to us to listen to these signals and figure out what the root cause is so that it can be eliminated.
If you spot any of these contamination indicators, it’s time to replace that waterpik.
Mold in a waterpik is something no one wants to deal with, and it’s definitely not what the dentists and oral hygienists recommended when they said to up your flossing game.

Not only is it bad for your health and can lead to other moldy problems developing elsewhere in the home, but it’s also super high on the icky scale. Just think of all of those little contaminants swishing through your mouth, sliding between your teeth, and making their way into your body.
That’s not ideal or sanitary, to say the least! Learning how mold in a waterpik occurs and how to prevent it can go a long way towards ensuring your dental routine is beneficial and not a particle-filled mouth bomb. Remembering to floss your teeth is hard enough. No need for mold to join the party.
Health begins at home. ™
A member of our team is here to help! Click on “Get Started ➤” below to book a consultation with a member of the HOMECLEANSE team. We have a few quick questions that will help us put together a roadmap to solve or prevent all of your mold problems.
Two minutes of your time could lead to better health for you and your family.

Add EC3 to every rinse cycle to rinse away mold, bacteria and musty odors from...
-
$23.00 Shop Now
Turn your HVAC into the healthiest feature of your home.
-
$2,495.00 Shop Now
Take your cleaning to the next level buying all the tools we use to keep...
-
Price range: $299.00 through $549.00 Shop Now
Remove harmful pollutants that accumulate in the dust of your home. (Options available for renters...
-
Price range: $99.00 through $349.00 Shop Now
Micro Balance EC3 Mold Solution Concentrate is a natural botanical that removes mold spores, bacteria,...
-
$33.00 Shop Now
Optimizing Air Quality starts with finding what’s not optimal. *Detects 36 different species of mold...
-
$299.00 Shop Now
The Euroclean GD930HSP is a 4 Gallon Dry HEPA Vacuum that meets the EPA's standards...
-
$849.00 Shop Now